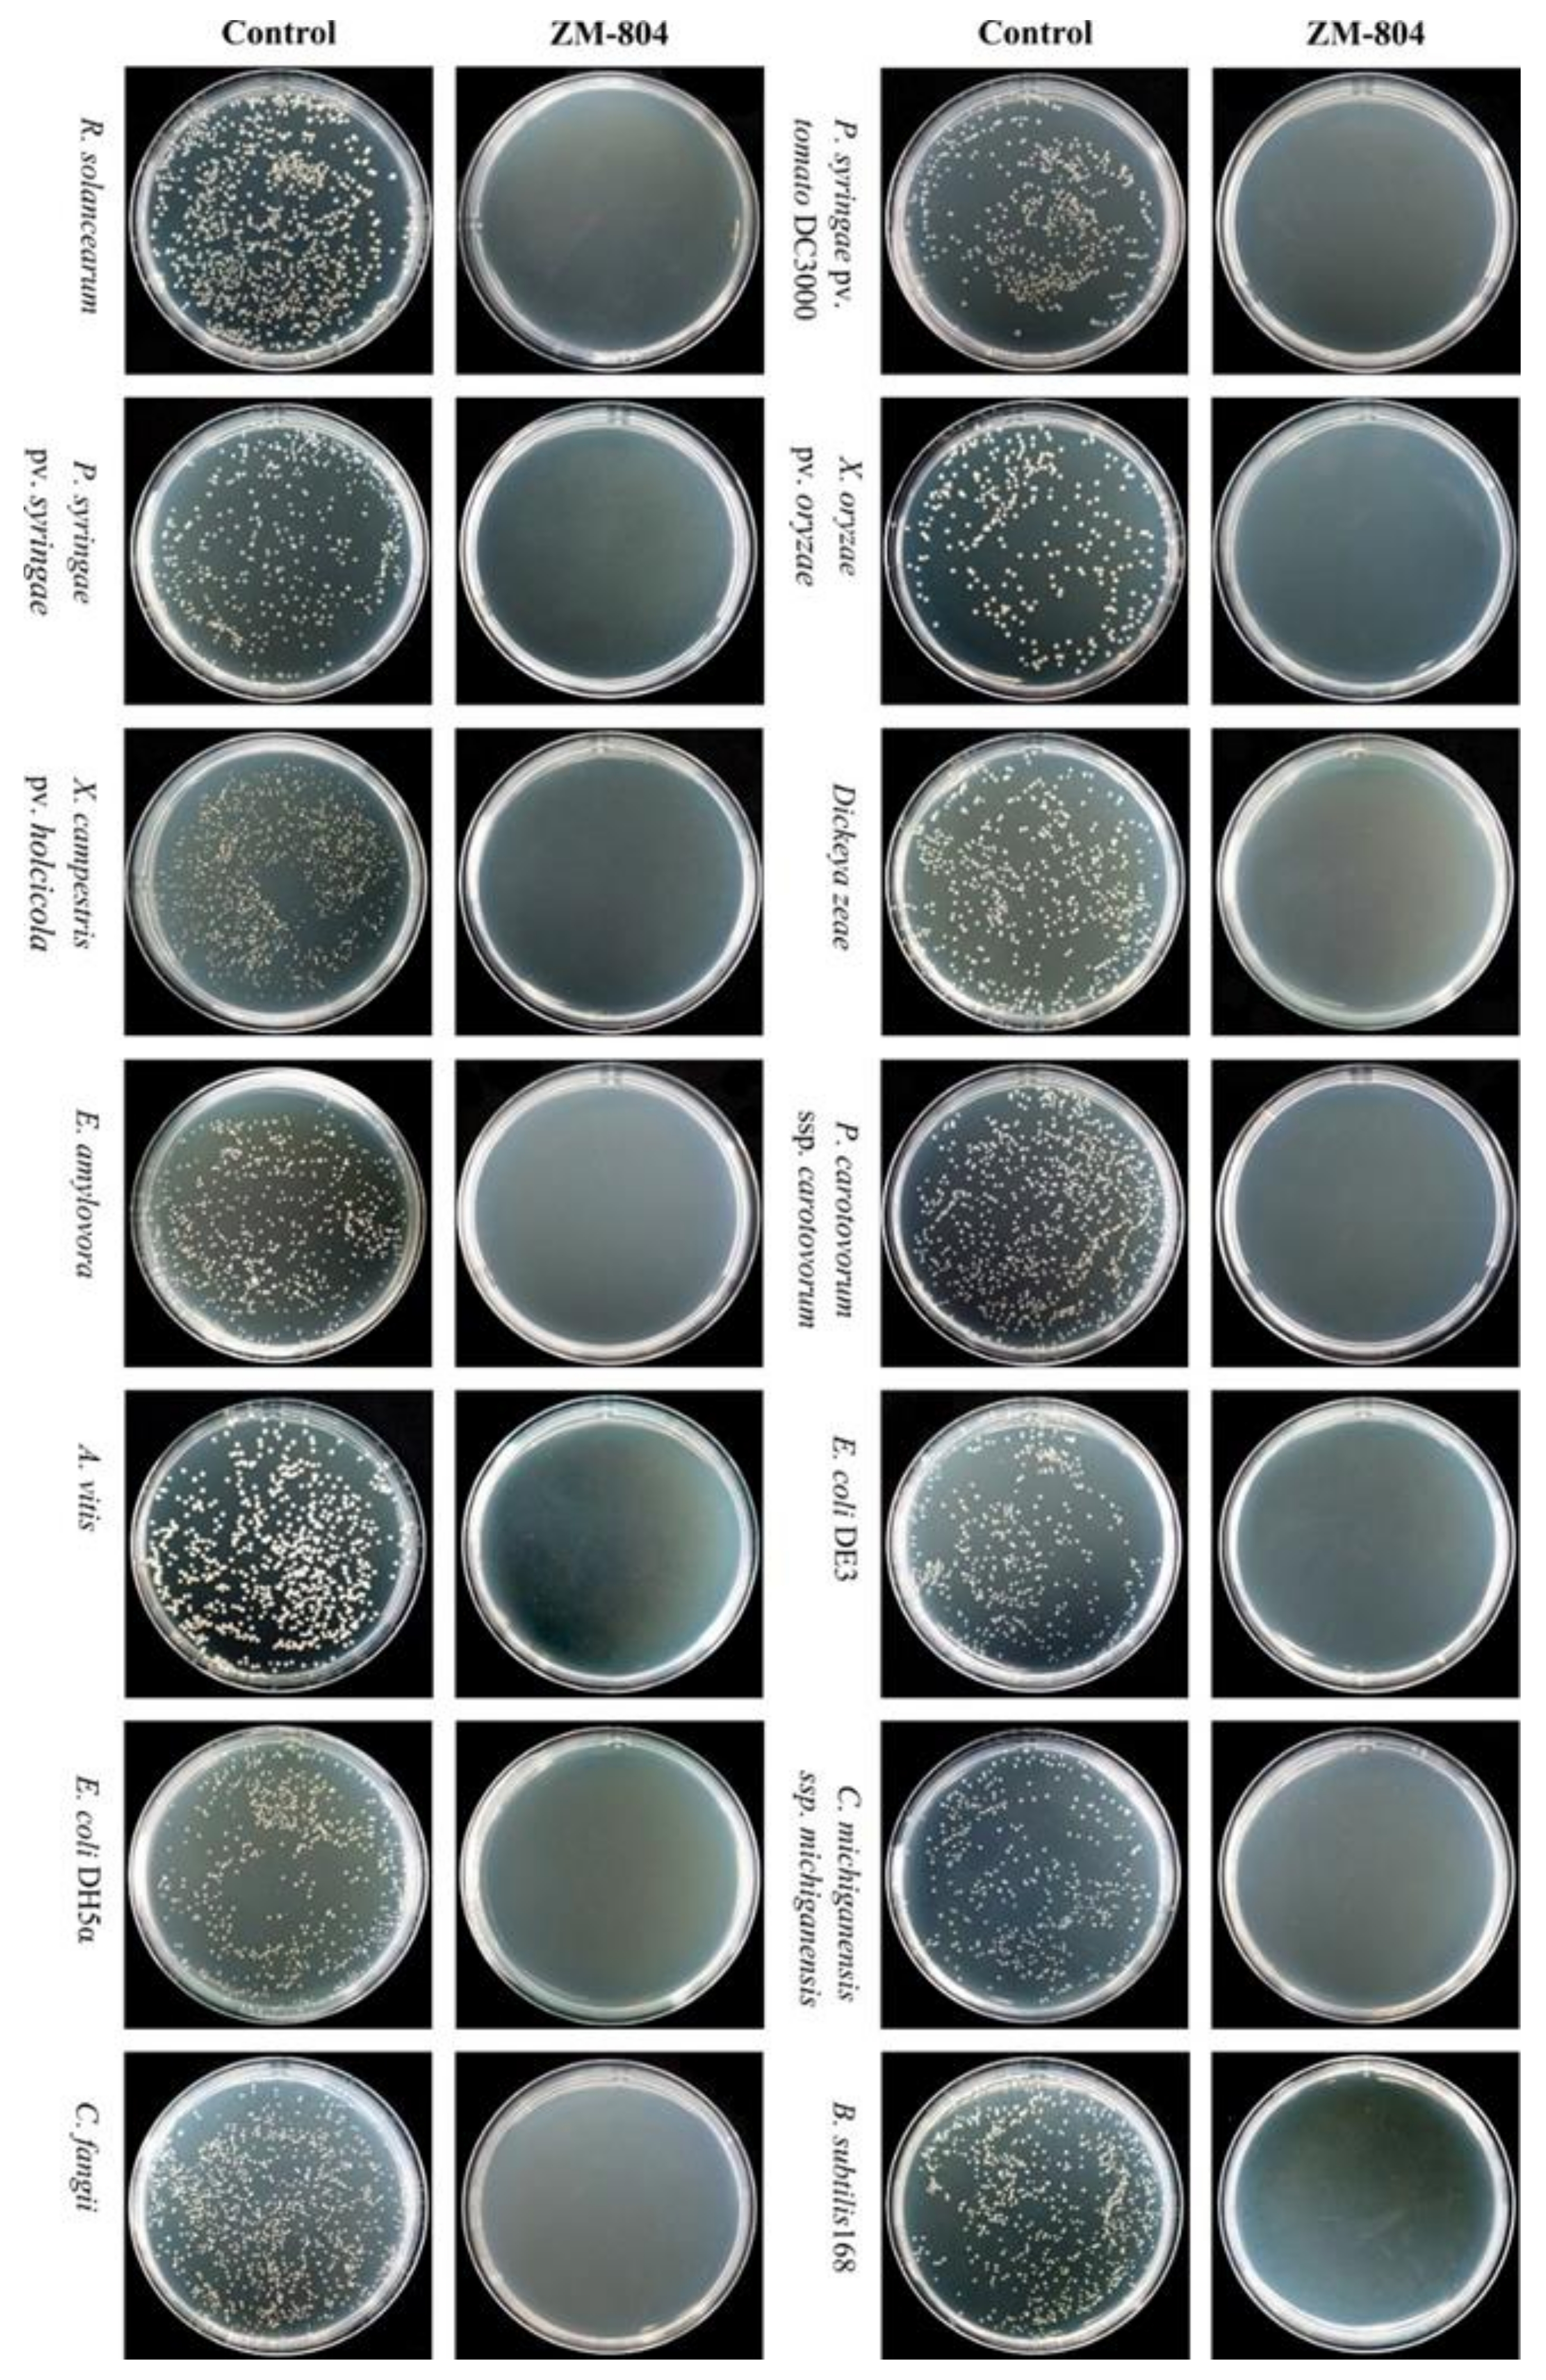
Ijms 22 02643 g002

Prediction and Activity of a Cationic α-Helix Antimicrobial Peptide ZM-804 from Maize
Abstract
1. Introduction
2. Results
2.1. cDNA Library of Maize B73
2.2. Bioinformatics Analysis
2.2.1. In Silico Prediction for AMPs
2.2.2. Physiochemical Characterization of the ZM-804 Peptide
2.2.3. The 3D Structure of ZM-804
2.3. Antimicrobial Assay of the ZM-804 Peptide
2.3.1. The MIC and MBC of the ZM-804 Peptide
2.3.2. The MLC of the ZM-804 Peptide
2.4. Localization of FITC-Labeled ZM-804 Peptide
2.5. Effect of the ZM-804 Peptide on Bacterial Cell Membranes
2.6. In Planta Antimicrobial Activity Assay of the ZM-804 Peptide
Hypersensitive Reaction (HR) on Nicotiana Benthamiana
2.7. Tomato Plant Infection Assay
Infection of P. syringae pv. Tomato DC3000 on Tomato
2.8. Hemolytic Activity of the ZM-804 Peptide
3. Discussion
4. Materials and Methods
4.1. Bacterial Strains and Growth Conditions
4.2. Construction of cDNA Library, Sequencing, and Analysis
4.3. Bioinformatics Analysis
4.3.1. In Silico Prediction for AMPs
4.3.2. Physiochemical Characterization of the ZM-804 Peptide
4.3.3. Prediction of 3D Structure
4.4. Synthesise of the ZM-804 Peptide
4.5. Antimicrobial Assay of the ZM-804 Peptide
4.5.1. Measuring the MIC and MBC of the ZM-804 Peptide
4.5.2. Measuring the MLC of the ZM-804 Peptide
4.6. FITC-Labeled ZM-804 Peptide
4.7. Observation of the Effects of the ZM-804 Peptide on Bacterial Cell Membranes
4.7.1. Scanning Electron Microscopy (SEM)
4.7.2. Transmission Electron Microscopy (TEM)
4.8. In planta Antimicrobial Activity Assay of the ZM-804 Peptide
Hypersensitive Reaction (HR) test on N. benthamiana
4.9. Tomato Plant Infection Assay
Infection of P. syringae pv. Tomato DC3000 on Tomato
4.10. Hemolytic Assays
5. Conclusions
Supplementary Materials
Author Contributions
Funding
Institutional Review Board Statement
Informed Consent Statement
Acknowledgments
Conflicts of Interest
References
- Riedl, S.; Zweytick, D.; Lohner, K. Membrane-Active Host Defense Peptides—Challenges and Perspectives for the Development of Novel Anticancer Drugs. Chem. Phys. Lipids 2011, 164, 766–781. [Google Scholar] [CrossRef] [PubMed]
- Huang, Y.; Huang, J.; Chen, Y. Alpha-Helical Cationic Antimicrobial Peptides: Relationships of Structure and Function. Protein Cell Rev. 2010, 1, 143–152. [Google Scholar] [CrossRef] [PubMed]
- Steinstraesser, L.; Kraneburg, U.M.; Hirsch, T.; Kesting, M.; Steinau, H.-U.; Jacobsen, F.; Al-Benna, S. Host Defense Peptides as Effector Molecules of the Innate Immune Response: A Sledgehammer for Drug Resistance? Int. J. Mol. Sci. 2009, 10, 3951–3970. [Google Scholar] [CrossRef] [PubMed]
- Reddick, L.E.; Alto, N.M. Bacteria Fighting Back: How Pathogens Target and Subvert the Host Innate Immune System. Mol. Cell 2014, 54, 321–328. [Google Scholar] [CrossRef]
- Hancock, R.E.; Haney, E.F.; Gill, E.E. The immunology of host defense peptides: Beyond antimicrobial activity. Nat. Rev. Immunol. 2016, 16, 321–334. [Google Scholar] [CrossRef] [PubMed]
- Oh, R.; Lee, M.J.; Kim, Y.-O.; Nam, B.-H.; Kong, H.J.; Kim, J.-W.; Park, J.-Y.; Seo, J.-K.; Kim, D.-G. Myticusin-beta, antimicrobial peptide from the marine bivalve, Mytilus coruscus. Fish Shellfish Immunol. 2020, 99, 342–352. [Google Scholar] [CrossRef]
- Pan, Q.; Wendel, J.; Fluhr, R. Divergent Evolution of Plant NBS-LRR Resistance Gene Homologues in Dicot and Cereal Genomes. J. Mol. Evol. 2000, 50, 203–213. [Google Scholar] [CrossRef] [PubMed]
- Duvick, J.; Rood, T.; Rao, A.; Marshak, D. Purification and characterization of a novel antimicrobial peptide from maize (Zea mays L.) kernels. J. Biol. Chem. 1992, 267, 18814–18820. [Google Scholar] [CrossRef]
- Bahar, A.A.; Ren, D. Antimicrobial Peptides. Pharmaceuticals 2013, 6, 1543–1575. [Google Scholar] [CrossRef]
- Weidmann, J.; Craik, D.J. Discovery, structure, function, and applications of cyclotides: Circular proteins from plants. J. Exp. Bot. 2016, 67, 4801–4812. [Google Scholar] [CrossRef] [PubMed]
- Hammami, R.; Ben Hamida, J.; Vergoten, G.; Fliss, I. PhytAMP: A database dedicated to antimicrobial plant peptides. Nucleic Acids Res. 2008, 37, D963–D968. [Google Scholar] [CrossRef] [PubMed]
- Jhong, J.-H.; Chi, Y.-H.; Li, W.-C.; Lin, T.-H.; Huang, K.-Y.; Lee, T.-Y. dbAMP: An integrated resource for exploring antimicrobial peptides with functional activities and physicochemical properties on transcriptome and proteome data. Nucleic Acids Res. 2019, 47, D285–D297. [Google Scholar] [CrossRef] [PubMed]
- Waghu, F.H.; Idicula-Thomas, S. Collection of antimicrobial peptides database and its derivatives: Applications and beyond. Protein Sci. 2020, 29, 36–42. [Google Scholar] [CrossRef] [PubMed]
- Wang, G.; Li, X.; Wang, Z. APD3: The antimicrobial peptide database as a tool for research and education. Nucleic Acids Res. 2016, 44, D1087–D1093. [Google Scholar] [CrossRef] [PubMed]
- Usmani, S.S.; Kumar, R.; Bhalla, S.; Kumar, V.; Raghava, G.P.S. In Silico Tools and Databases for Designing Peptide-Based Vaccine and Drugs. In Advances in Protein Chemistry and Structural Biology; Academic Press: Cambridge, MA, USA, 2018; Volume 112, pp. 221–263. [Google Scholar] [CrossRef]
- Takahashi, D.; Shukla, S.K.; Prakash, O.; Zhang, G. Structural determinants of host defense peptides for antimicrobial activity and target cell selectivity. Biochimie 2010, 92, 1236–1241. [Google Scholar] [CrossRef] [PubMed]
- Dathe, M.; Schümann, M.; Wieprecht, T.; Winkler, A.; Beyermann, M.; Krause, E.; Matsuzaki, K.; Murase, O.; Bienert, M. Peptide Helicity and Membrane Surface Charge Modulate the Balance of Electrostatic and Hydrophobic Interactions with Lipid Bilayers and Biological Membranes. Biochemistry 1996, 35, 12612–12622. [Google Scholar] [CrossRef] [PubMed]
- Giangaspero, A.; Sandri, L.; Tossi, A. Amphipathic Alpha Antimicrobial Peptides. Eur. J. Biochem. 2001, 268, 5589–5600. [Google Scholar] [CrossRef] [PubMed]
- Jindal, M.H.; Le, C.F.; Mohd Yusof, M.Y.; Sekaran, S.D. Net Charge, Hydrophobicity and Specific Amino Acids Contribute to the Activity of Antimicrobial Peptides. J. Health Transl. Med. 2014, 17, 1–7. [Google Scholar] [CrossRef]
- Clinical and Laboratory Standards Institute. M02 Performance Standards for Antimicrobial Disk Susceptibility Tests, 13th ed.; CLSI: Wayne, PA, USA, 2018. [Google Scholar]
- Farkas, A.; Maróti, G.; Kereszt, A.; Kondorosi, É. Comparative Analysis of the Bacterial Membrane Disruption Effect of Two Natural Plant Antimicrobial Peptides. Front. Microbiol. 2017, 8, 51. [Google Scholar] [CrossRef]
- Sinha, S.; Zheng, L.; Mu, Y.; Ng, W.J.; Bhattacharjya, S. Structure and Interactions of A Host Defense Antimicrobial Peptide Thanatin in Lipopolysaccharide Micelles Reveal Mechanism of Bacterial Cell Agglutination. Sci. Rep. 2017, 7, 1–13. [Google Scholar] [CrossRef] [PubMed]
- Tolba, I.; Zaki, M. Characterization of Agrobacterium vitis isolates obtained from galled grapevine plants in Egypt. Ann. Agric. Sci. 2011, 56, 113–119. [Google Scholar] [CrossRef][Green Version]
- Kannan, V.R. Quorum Sensing in Plant Pathogenic and Plant-Associated Bacteria. In Sustainable Approaches to Controlling Plant Pathogenic Bacteria; Kannan, V.R., Bastas, K.K., Eds.; CRC Press: Boca Raton, FL, USA, 2015. [Google Scholar] [CrossRef]
- Daoubi, M.; Hernández-Galán, R.; Benharref, A.; Collado, I.G. Screening Study of Lead Compounds for Natural Product-Based Fungicides: Antifungal Activity and Biotransformation of 6α,7α-Dihydroxy-β-himachalene byBotrytis cinerea. J. Agric. Food Chem. 2005, 53, 6673–6677. [Google Scholar] [CrossRef] [PubMed]
- Würz, J.M.; Güntert, P. Peak picking multidimensional NMR spectra with the contour geometry based algorithm CYPICK. J. Biomol. NMR 2017, 67, 63–76. [Google Scholar] [CrossRef]
- Sippl, M.J. Recognition of errors in three-dimensional structures of proteins. Proteins Struct. Funct. Bioinform. 1993, 17, 355–362. [Google Scholar] [CrossRef]
- Chen, V.B.; Arendall, W.B.; Headd, J.J.; Keedy, D.A.; Immormino, R.M.; Kapral, G.J.; Murray, L.W.; Richardson, J.S.; Richardson, D.C. MolProbity: All-atom structure validation for macromolecular crystallography. Acta Crystallogr. Sect. D Biol. Crystallogr. 2009, 66, 12–21. [Google Scholar] [CrossRef]
- Agrios, G. Plant Pathology, 5th ed.; Academic Press: Cambridge, MA, USA, 2004; Volume 9780080473789. [Google Scholar] [CrossRef]
- Meyers, B.C.; Dickerman, A.W.; Michelmore, R.W.; Sivaramakrishnan, S.; Sobral, B.W.; Young, N.D. Plant disease resistance genes encode members of an ancient and diverse protein family within the nucleotide-binding superfamily. Plant J. 1999, 20, 317–332. [Google Scholar] [CrossRef] [PubMed]
- Zhao, B.; Lin, X.; Poland, J.; Trick, H.; Leach, J.; Hulbert, S. A maize resistance gene functions against bacterial streak disease in rice. Proc. Natl. Acad. Sci. USA 2005, 102, 15383–15388. [Google Scholar] [CrossRef]
- Liu, S.; Fan, L.; Sun, J.; Lao, X.; Zheng, H. Computational resources and tools for antimicrobial peptides. J. Pept. Sci. 2017, 23, 4–12. [Google Scholar] [CrossRef]
- Nawrot, R.; Barylski, J.; Nowicki, G.; Broniarczyk, J.; Buchwald, W.; Goździcka-Józefiak, A. Plant antimicrobial peptides. Folia Microbiol. 2014, 59, 181–196. [Google Scholar] [CrossRef]
- Reddy, K.; Yedery, R.; Aranha, C. Antimicrobial peptides: Premises and promises. Int. J. Antimicrob. Agents 2004, 24, 536–547. [Google Scholar] [CrossRef] [PubMed]
- Ong, Z.Y.; Cheng, J.; Huang, Y.; Xu, K.; Ji, Z.; Fan, W.; Yang, Y.Y. Effect of stereochemistry, chain length and sequence pattern on antimicrobial properties of short synthetic β-sheet forming peptide amphiphiles. Biomaterials 2014, 35, 1315–1325. [Google Scholar] [CrossRef]
- Yount, N.Y.; Bayer, A.S.; Xiong, Y.Q.; Yeaman, M.R. Advances in antimicrobial peptide immunobiology. Pept. Sci. Orig. Res. Biomol. 2006, 84, 435–458. [Google Scholar] [CrossRef]
- Sitaram, N.; Nagaraj, R. Host-defense Antimicrobial Peptides: Importance of Structure for Activity. Curr. Pharm. Des. 2002, 8, 727–742. [Google Scholar] [CrossRef] [PubMed]
- Fernandez, D.I.; Lee, T.-H.; Sani, M.-A.; Aguilar, M.-I.; Separovic, F. Proline Facilitates Membrane Insertion of the Antimicrobial Peptide Maculatin 1.1 via Surface Indentation and Subsequent Lipid Disordering. Biophys. J. 2013, 104, 1495–1507. [Google Scholar] [CrossRef]
- He, J.; Luo, X.; Jin, D.; Wang, Y.; Zhang, T. Identification, Recombinant Expression, and Characterization of LGH2, a Novel Antimicrobial Peptide of Lactobacillus casei HZ1. Molecules 2018, 23, 2246. [Google Scholar] [CrossRef] [PubMed]
- Park, C.B.; Yi, K.-S.; Matsuzaki, K.; Kim, M.S.; Kim, S.C. Structure—Activity analysis of buforin II, a histone H2A-derived antimicrobial peptide: The proline hinge is responsible for the cell-penetrating ability of buforin II. Proc. Natl. Acad. Sci. USA 2000, 97, 8245–8250. [Google Scholar] [CrossRef]
- Tam, J.P.; Wang, S.; Wong, K.H.; Tan, W.L. Antimicrobial Peptides from Plants. Pharmaceuticals 2015, 8, 711–757. [Google Scholar] [CrossRef] [PubMed]
- Bonduelle, C. Secondary Structures of Synthetic Polypeptide Polymers. Polym. Chem. 2018, 9, 1517–1529. [Google Scholar] [CrossRef]
- Gómez-Sequeda, N.; Ruiz, J.; Ortiz, C.; Urquiza, M.; Torres, R. Potent and Specific Antibacterial Activity against Escherichia Coli O157:H7 and Methicillin Resistant Staphylococcus Aureus (Mrsa) of G17 and G19 Peptides Encapsulated into Poly-Lactic-Co-Glycolic Acid (Plga) Nanoparticles. Antibiotics 2020, 9, 384. [Google Scholar] [CrossRef]
- Mäde, V.; Els-Heindl, S.; Beck-Sickinger, A.G. Automated solid-phase peptide synthesis to obtain therapeutic peptides. Beilstein J. Org. Chem. 2014, 10, 1197–1212. [Google Scholar] [CrossRef] [PubMed]
- Qutb, A.M.; Wei, F.; Dong, W. Prediction and Characterization of Cationic Arginine-Rich Plant Antimicrobial Peptide SM-985 From Teosinte (Zea mays ssp. mexicana). Front. Microbiol. 2020, 11, 1353. [Google Scholar] [CrossRef]
- Domhan, C.; Uhl, P.; Meinhardt, A.; Zimmermann, S.; Kleist, C.; Lindner, T.; Leotta, K.; Mier, W.; Wink, M. A novel tool against multiresistant bacterial pathogens: Lipopeptide modification of the natural antimicrobial peptide ranalexin for enhanced antimicrobial activity and improved pharmacokinetics. Int. J. Antimicrob. Agents 2018, 52, 52–62. [Google Scholar] [CrossRef] [PubMed]
- Farkas, A.; Pap, B.; Kondorosi, É.; Maróti, G. Antimicrobial Activity of NCR Plant Peptides Strongly Depends on the Test Assays. Front. Microbiol. 2018, 9, 2600. [Google Scholar] [CrossRef] [PubMed]
- Yang, S.-T.; Lee, J.Y.; Kim, H.-J.; Eu, Y.-J.; Shin, S.Y.; Hahm, K.-S.; Kim, J.I. Contribution of a central proline in model amphipathic α-helical peptides to self-association, interaction with phospholipids, and antimicrobial mode of action. FEBS J. 2006, 273, 4040–4054. [Google Scholar] [CrossRef]
- Silhavy, T.J.; Kahne, D.; Walker, S. The bacterial cell envelope. Cold Spring Harb. Perspect. Biol. 2010, 2, 1–16. [Google Scholar] [CrossRef] [PubMed]
- Clinical and Laboratory Standards Institute. Methods for Determining Bactericidal Activity of Antimicrobial Agents: Approved Guideline; CLSI Document M26-A; CLSI: Wayne, PA, USA, 1999. [Google Scholar]
- Chang, T.-W.; Lin, Y.-M.; Wang, C.-F.; Liao, Y.-D. Outer Membrane Lipoprotein Lpp Is Gram-negative Bacterial Cell Surface Receptor for Cationic Antimicrobial Peptides. J. Biol. Chem. 2012, 287, 418–428. [Google Scholar] [CrossRef]
- Zhu, X.; Dong, N.; Wang, Z.; Ma, Z.; Zhang, L.; Ma, Q.; Shan, A. Design of imperfectly amphipathic α-helical antimicrobial peptides with enhanced cell selectivity. Acta Biomater. 2014, 10, 244–257. [Google Scholar] [CrossRef]
- Hong, J.; Guan, W.; Jin, G.; Zhao, H.; Jiang, X.; Dai, J. Mechanism of tachyplesin I injury to bacterial membranes and intracellular enzymes, determined by laser confocal scanning microscopy and flow cytometry. Microbiol. Res. 2015, 170, 69–77. [Google Scholar] [CrossRef]
- Bhunia, A.; Ramamoorthy, A.; Bhattacharjya, S. Helical Hairpin Structure of a Potent Antimicrobial Peptide MSI-594 in Lipopolysaccharide Micelles by NMR Spectroscopy. Chem. A Eur. J. 2009, 15, 2036–2040. [Google Scholar] [CrossRef] [PubMed]
- Van De Velde, W.; Zehirov, G.; Szatmari, A.; Debreczeny, M.; Ishihara, H.; Kevei, Z.; Farkas, A.; Mikulass, K.; Nagy, A.; Tiricz, H.; et al. Plant Peptides Govern Terminal Differentiation of Bacteria in Symbiosis. Science 2010, 327, 1122–1126. [Google Scholar] [CrossRef]
- Dash, R.; Bhattacharjya, S. Thanatin: An Emerging Host Defense Antimicrobial Peptide with Multiple Modes of Action. Int. J. Mol. Sci. 2021, 22, 1522. [Google Scholar] [CrossRef]
- Hartmann, M.; Berditsch, M.; Hawecker, J.; Ardakani, M.F.; Gerthsen, D.; Ulrich, A.S. Damage of the Bacterial Cell Envelope by Antimicrobial Peptides Gramicidin S and PGLa as Revealed by Transmission and Scanning Electron Microscopy. Antimicrob. Agents Chemother. 2010, 54, 3132–3142. [Google Scholar] [CrossRef]
- Liu, W.-P.; Chen, Y.-H.; Ming, X.; Kong, Y. Design and Synthesis of a Novel Cationic Peptide with Potent and Broad-Spectrum Antimicrobial Activity. BioMed Res. Int. 2015, 2015, 578764. [Google Scholar] [CrossRef] [PubMed]
- Rico, A.; Preston, G.M. Pseudomonas syringae pv. tomato DC3000 Uses Constitutive and Apoplast-Induced Nutrient Assimilation Pathways to Catabolize Nutrients That Are Abundant in the Tomato Apoplast. Mol. Plant Microbe Interact. 2008, 21, 269–282. [Google Scholar] [CrossRef] [PubMed]
- Cai, R.; Lewis, J.; Yan, S.; Liu, H.; Clarke, C.R.; Campanile, F.; Almeida, N.F.; Studholme, D.J.; Lindeberg, M.; Schneider, D.; et al. The Plant Pathogen Pseudomonas syringae pv. tomato Is Genetically Monomorphic and under Strong Selection to Evade Tomato Immunity. PLoS Pathog. 2011, 7, e1002130. [Google Scholar] [CrossRef]
- Morassutti, C.; De Amicis, F.; Skerlavaj, B.; Zanetti, M.; Marchetti, S. Production of a recombinant antimicrobial peptide in transgenic plants using a modified VMA intein expression system. FEBS Lett. 2002, 519, 141–146. [Google Scholar] [CrossRef]
- Datta, A.; Ghosh, A.; Airoldi, C.; Sperandeo, P.; Mroue, K.H.; Jiménez-Barbero, J.; Kundu, P.; Ramamoorthy, A.; Bhunia, A. Antimicrobial Peptides: Insights into Membrane Permeabilization, Lipopolysaccharide Fragmentation and Application in Plant Disease Control. Sci. Rep. 2015, 5, srep11951. [Google Scholar] [CrossRef] [PubMed]
- Yin, L.M.; Edwards, M.A.; Li, J.; Yip, C.M.; Deber, C.M. Roles of Hydrophobicity and Charge Distribution of Cationic Antimicrobial Peptides in Peptide-Membrane Interactions. J. Biol. Chem. 2012, 287, 7738–7745. [Google Scholar] [CrossRef]
- Jiang, Z.; Vasil, A.I.; Hale, J.D.; Hancock, R.E.W.; Vasil, M.L.; Hodges, R.S. Effects of Net Charge and the Number of Positively Charged Residues on the Biological Activity of Amphipathic α-Helical Cationic Antimicrobial Peptides. Peptide Sci. 2008, 90, 369–383. [Google Scholar] [CrossRef] [PubMed]
- Huan, J.; Wan, K.; Liu, Y.; Dong, W.; Wang, G. Removing PCR for the elimination of undesired DNA fragments cycle by cycle. Sci. Rep. 2013, 3, srep02303. [Google Scholar] [CrossRef]
- Yang, L.Y.; Yang, S.L.; Li, J.Y.; Ma, J.H.; Pang, T.; Zou, C.M.; He, B.; Gong, M. Effects of different growth temperatures on growth, development, and plastid pigments metabolism of tobacco (Nicotiana tabacum L.) plants. Bot. Stud. 2018, 59, 5. [Google Scholar] [CrossRef]
- Kong, X.; Yang, M.; Abbas, H.M.K.; Wu, J.; Li, M.; Dong, W. Antimicrobial genes from Allium sativum and Pinellia ternata revealed by a Bacillus subtilis expression system. Sci. Rep. 2018, 8, 14514. [Google Scholar] [CrossRef] [PubMed]
- Wu, J.; Abbas, H.M.K.; Li, J.; Yuan, Y.; Liu, Y.; Wang, G.; Dong, W. Cell Membrane-Interrupting Antimicrobial Peptides from Isatis Indigotica Fortune Isolated by a Bacillus Subtilis Expression System. Biomolecules 2020, 10, 30. [Google Scholar] [CrossRef]
- Li, J.; Islam, S.; Guo, P.; Hu, X.; Dong, W. Isolation of Antimicrobial Genes from Oryza rufipogon Griff by Using a Bacillus subtilis Expression System with Potential Antimicrobial Activities. Int. J. Mol. Sci. 2020, 21, 8722. [Google Scholar] [CrossRef]
- Andorf, C.M.; Cannon, E.K.; Portwood, J.L.; Gardiner, J.M.; Harper, L.C.; Schaeffer, M.L.; Braun, B.L.; Campbell, D.A.; Vinnakota, A.G.; Sribalusu, V.V.; et al. MaizeGDB update: New tools, data and interface for the maize model organism database. Nucleic Acids Res. 2015, 44, D1195–D1201. [Google Scholar] [CrossRef]
- Osawa, S.; Muto, A.; Jukes, T.H.; Ohama, T. Evolutionary changes in the genetic code. Proc. R. Soc. B Boil. Sci. 1990, 241, 19–28. [Google Scholar] [CrossRef]
- Lee, H.-T.; Lee, C.-C.; Yang, J.-R.; Lai, J.Z.C.; Chang, K.Y. A Large-Scale Structural Classification of Antimicrobial Peptides. BioMed Res. Int. 2015, 2015, 475062. [Google Scholar] [CrossRef]
- Grafskaia, E.N.; Polina, N.F.; Babenko, V.V.; Kharlampieva, D.D.; Bobrovsky, P.A.; Manuvera, V.A.; Farafonova, T.E.; Anikanov, N.A.; Lazarev, V.N. Discovery of novel antimicrobial peptides: A transcriptomic study of the sea anemone Cnidopus japonicus. J. Bioinform. Comput. Biol. 2018, 16, 1840006. [Google Scholar] [CrossRef]
- Joseph, S.; Karnik, S.; Nilawe, P.; Jayaraman, V.K.; Idicula-Thomas, S. ClassAMP: A Prediction Tool for Classification of Antimicrobial Peptides. IEEE ACM Trans. Comput. Biol. Bioinform. 2012, 9, 1535–1538. [Google Scholar] [CrossRef]
- Lata, S.; Sharma, B.; Raghava, G. Analysis and prediction of antibacterial peptides. BMC Bioinform. 2007, 8, 263. [Google Scholar] [CrossRef]
- Meher, P.K.; Sahu, T.K.; Rao, A.R. Performance evaluation of neural network, support vector machine and random forest for prediction of donor splice sites in rice. Indian J. Genet. Plant Breed. 2016, 76, 173. [Google Scholar] [CrossRef]
- Gautier, R.; Douguet, D.; Antonny, B.; Drin, G. HELIQUEST: A web server to screen sequences with specific α-helical properties. Bioinformatics 2008, 24, 2101–2102. [Google Scholar] [CrossRef]
- Keller, R.C. New User-Friendly Approach to Obtain an Eisenberg Plot and Its Use as a Practical Tool in Protein Sequence Analysis. Int. J. Mol. Sci. 2011, 12, 5577–5591. [Google Scholar] [CrossRef] [PubMed]
- Roy, A.; Kucukural, A.; Zhang, Y. I-TASSER: A unified platform for automated protein structure and function prediction. Nat. Protoc. 2010, 5, 725–738. [Google Scholar] [CrossRef] [PubMed]
- Lamiable, A.; Thévenet, P.; Rey, J.; Vavrusa, M.; Derreumaux, P.; Tufféry, P. PEP-FOLD3: Fasterde novostructure prediction for linear peptides in solution and in complex. Nucleic Acids Res. 2016, 44, W449–W454. [Google Scholar] [CrossRef]
- Wiederstein, M.; Sippl, M.J. ProSA-web: Interactive web service for the recognition of errors in three-dimensional structures of proteins. Nucleic Acids Res. 2007, 35, W407–W410. [Google Scholar] [CrossRef] [PubMed]
- Clinical and Laboratory Standards Institute. M07-A9: Methods for Dilution Antimicrobial Susceptibility Tests for Bacteria That Grow Aerobically; Approved Standard, 9th ed.; CLSI: Wayne, PA, USA, 2012; Volume 32. [Google Scholar]
- Wu, X.; Wang, Z.; Li, X.; Fan, Y.; He, G.; Wan, Y.; Yu, C.; Tang, J.; Li, M.; Zhang, X.; et al. In VitroandIn VivoActivities of Antimicrobial Peptides Developed Using an Amino Acid-Based Activity Prediction Method. Antimicrob. Agents Chemother. 2014, 58, 5342–5349. [Google Scholar] [CrossRef]
- European Committee for Antimicrobial Susceptibility Testing (EUCAST) of the European Society of Clinical Microbiology and Infectious Diseases (ESCMID). Determination of minimum inhibitory concentrations (MICs) of antibacterial agents by broth dilution. Clin. Microbiol. Infect. 2003, 9, 9–15. [Google Scholar]
- Ribeiro, C.W.; Baldacci-Cresp, F.; Pierre, O.; Larousse, M.; Benyamina, S.; Lambert, A.; Hopkins, J.; Castella, C.; Cazareth, J.; Alloing, G.; et al. Regulation of Differentiation of Nitrogen-Fixing Bacteria by Microsymbiont Targeting of Plant Thioredoxin s1. Curr. Biol. 2017, 27, 250–256. [Google Scholar] [CrossRef] [PubMed]
- Saikia, K.; Sravani, Y.D.; Ramakrishnan, V.; Chaudhary, N. Highly potent antimicrobial peptides from N-terminal membrane-binding region of E. coli MreB. Sci. Rep. 2017, 7, srep42994. [Google Scholar] [CrossRef]
- Ferreira, S.; Silva, F.; Queiroz, J.A.; Oleastro, M.; Domingues, F.C. Resveratrol against Arcobacter butzleri and Arcobacter cryaerophilus: Activity and effect on cellular functions. Int. J. Food Microbiol. 2014, 180, 62–68. [Google Scholar] [CrossRef] [PubMed]
- Shi, W.; Li, C.; Li, M.; Zong, X.; Han, D.; Chen, Y. Antimicrobial peptide melittin against Xanthomonas oryzae pv. oryzae, the bacterial leaf blight pathogen in rice. Appl. Microb. Cell Physiol. 2016, 100, 5059–5067. [Google Scholar] [CrossRef] [PubMed]
- Mohanram, H.; Bhattacharjya, S. ‘Lollipop’-shaped helical structure of a hybrid antimicrobial peptide of temporin B-lipopolysaccharide binding motif and mapping cationic residues in antibacterial activity. Biochim. Biophys. Acta Gen. Subj. 2016, 1860, 1362–1372. [Google Scholar] [CrossRef] [PubMed]

| Primary Structure | LARLRRLCFLWAAAWPWPWR |
|---|---|
| Hydrophobic amino acid | I: 0, V: 0, L: 4, F: 1, C: 1, M: 0, A: 4, W: 4 |
| MW (Da) | 2569.131 |
| Net charge | +4 |
| Total hydrophobic ratio | 70% |
| Protein-binding potential (Boman index) kcal/mol | 0.95 |
| GRAVY | 0.145 |
| Bacterial Indicators | MIC | MBC |
|---|---|---|
| C. michiganensis subsp. michiganensis | 8 | 16 |
| C. fangii | 8 | 16 |
| Bacillus subtilis 168 | 16 | 32 |
| R. solanacearum | 8 | 16 |
| P. syringae pv. tomato DC3000 | 4 | 8 |
| P. syringae pv. syringae | 4 | 8 |
| X. oryzae pv. oryzae | 4 | 8 |
| X. campestris pv. holcicola | 4 | 8 |
| Dickeya zeae | 16 | 32 |
| P. carotovorum subsp. carotovorum | 16 | 32 |
| Erwinia amylovora | 8 | 16 |
| Agrobacterium vitis | 8 | 16 |
| E. coli DH5α | 16 | 32 |
| E. coli DE3 | 16 | 32 |
Publisher’s Note: MDPI stays neutral with regard to jurisdictional claims in published maps and institutional affiliations. |
© 2021 by the authors. Licensee MDPI, Basel, Switzerland. This article is an open access article distributed under the terms and conditions of the Creative Commons Attribution (CC BY) license (http://creativecommons.org/licenses/by/4.0/).
Share and Cite
Hassan, M.F.; Qutb, A.M.; Dong, W. Prediction and Activity of a Cationic α-Helix Antimicrobial Peptide ZM-804 from Maize. Int. J. Mol. Sci. 2021, 22, 2643. https://doi.org/10.3390/ijms22052643
Hassan MF, Qutb AM, Dong W. Prediction and Activity of a Cationic α-Helix Antimicrobial Peptide ZM-804 from Maize. International Journal of Molecular Sciences. 2021; 22(5):2643. https://doi.org/10.3390/ijms22052643
Chicago/Turabian StyleHassan, Mohamed F., Abdelrahman M. Qutb, and Wubei Dong. 2021. "Prediction and Activity of a Cationic α-Helix Antimicrobial Peptide ZM-804 from Maize" International Journal of Molecular Sciences 22, no. 5: 2643. https://doi.org/10.3390/ijms22052643
APA StyleHassan, M. F., Qutb, A. M., & Dong, W. (2021). Prediction and Activity of a Cationic α-Helix Antimicrobial Peptide ZM-804 from Maize. International Journal of Molecular Sciences, 22(5), 2643. https://doi.org/10.3390/ijms22052643

